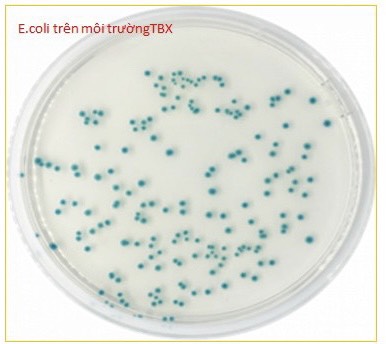

Khi tiến hành thử nghiệm vi khuẩn E.coli trong mẫu thực phẩm, mẫu nước có nhiều phương pháp thử nghiệm khác nhau, phụ thuộc vào cơ chế của từng phương pháp thử nghiệm, như thử nghiệm E.coli giả định, E.coli dương tính với ß-glucuronidase hoặc định lượng tổng E.coli.
Việc lựa chọn các kỹ thuật thử nghiệm khác nhau phụ thuộc vào mục đích thử nghiệm và căn cứ đánh giá kết quả thử nghiệm.
- Đối với phương pháp thử nghiệm E.coli giả định, bản chất của phương pháp là đánh giá khả năng lên men lactoza của vi khuẩn, sinh khí và sinh indol từ tryptophan ở 44°C. Vì vậy, khi kết quả có phát hiện E.coli giả định thì vẫn có khả năng mẫu thử không nhiễm E.coli thực sự. Mục đích của phương pháp này là sàng lọc khả năng phát hiện của vi khuẩn E.coli trong mẫu. Đối với phương pháp thử nghiệm E.coli dương tính với ß-glucuronidase (GUD), bản chất của phương pháp là theo dõi các chủng E.coli hình thành các khuẩn lạc màu xanh lam/xanh da trời trên môi trường thạch Tryptone Bile X-glucuronide (TBX) ở nhiệt độ 44°C. Điều này được giải thích vì có 96 đến 97% E.coli có chứa enzyme GUD và enzyme này có khả năng phân giải đặc hiệu với cơ chất 5-Bromo-4-Chloro-3-Indolyl-ß-D-Glucuronide được bổ sung vào TBX agar. Như vậy, khi tiến hành thử nghiệm bằng phương pháp E.coli dương tính với ß-glucuronidase có kết quả âm tính thì chưa hẳn mẫu thử nghiệm không bị nhiễm vi khuẩn E.coli, vì có khoảng 3 đến 4% chúng ta "bỏ quên" các chủng E.coli khác không đặc hiệu với phương pháp thử nghiệm này.
- Ngoài ra, để thử nghiệm xác định vi khuẩn E.coli, thì chúng ta phải thử nghiệm hàng loạt các phản ứng sinh hóa, cơ bản nhất vẫn là IMViC (Indol, Methylred, Voges prokauer và khả năng sử dụng Citrate), phương pháp thử bằng PCR/Realtime PCR hoặc giải trình tự gen để gọi tên đích danh.
- Đối với mẫu nước có 2 phương pháp thử nghiệm vi khuẩn E.coli thường được áp dụng là: Phương pháp màng lọc, áp dụng đối với mẫu nước sạch (nước uống đóng chai, nước vòi, nước sản xuất, nước đá, nước ngầm, nước chứa lượng vi sinh vật thấp) tính theo đơn vị CFU/ml và Phương pháp đếm số có xác xuất lớn nhất, áp dụng đối với nền mẫu nước thải, nước mặt, ao hồ, nước chứa hàm lượng vi sinh vật cao, tính theo đơn vị MPN/ml.
Hiện nay, Trung tâm Kỹ thuật Tiêu chuẩn Đo lường Chất lượng Bình Thuận đã triển khai các phương pháp thử nghiệm vi sinh vật nói chung, vi khuẩn E.Coli trong mẫu thực phẩm, mẫu nước nói riêng, được chứng nhận theo hệ thống ISO 17025 và được các cơ quan có thẩm quyền chứng nhận/chỉ định thử nghiệm. Định kỳ, Trung tâm có tổ chức các khóa đào tạo thử nghiệm hóa lý/vi sinh tại chỗ, hướng dẫn cho học viên thành thạo tay nghề. Các tổ chức, cá nhân có nhu cầu vui lòng liên hệ để được tư vấn và hướng dẫn.
Mọi chi tiết vui lòng liên hệ:
Trung tâm Kỹ thuật Tiêu chuẩn Đo lường Chất lượng Bình Thuận
Địa chỉ: Khu dân cư Bắc Xuân An – P. Xuân An – TP. Phan Thiết – Bình Thuận
Điện thoại: 0252 3822390 – 0908 700379
Website: tdcbinhthuan.vn
Email: trungtamtdc.binhthuan@gmail.com
Ngọc Yến